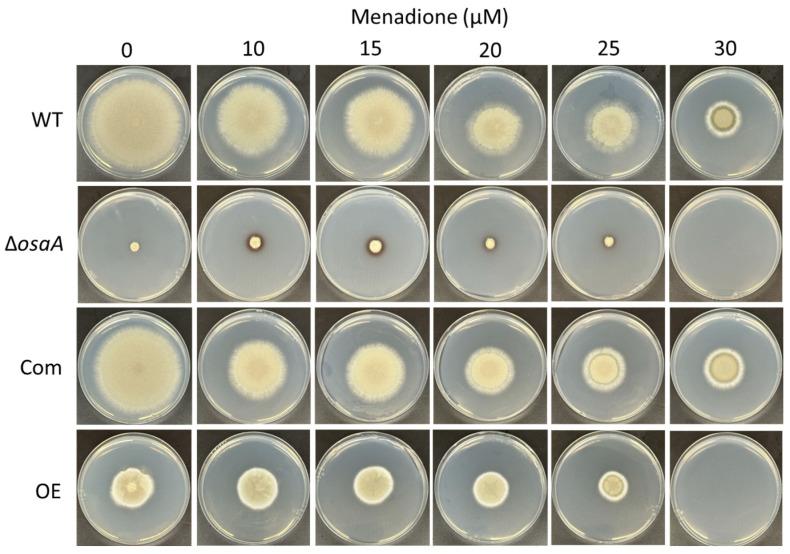

该基因在发育、次生代谢和毒力中的作用。
Role of the Gene in Development, Secondary Metabolism and Virulence.
作者信息
Dabholkar Apoorva, Pandit Sandesh, Devkota Ritu, Dhingra Sourabh, Lorber Sophie, Puel Olivier, Calvo Ana M
机构信息
Department of Biological Sciences, Northern Illinois University, DeKalb, IL 60115, USA.
Department of Biological Sciences and Eukaryotic Pathogen Innovation Center, Clemson University, Clemson, SC 29634, USA.
出版信息
J Fungi (Basel). 2024 Jan 26;10(2):103. doi: 10.3390/jof10020103.
is the leading cause of aspergillosis, associated with high mortality rates, particularly in immunocompromised individuals. In search of novel genetic targets against aspergillosis, we studied the WOPR transcription factor OsaA. The deletion of the gene resulted in colony growth reduction. Conidiation is also influenced by ; both deletion and overexpression resulted in a decrease in spore production. Wild-type expression levels of are necessary for the expression of the conidiation regulatory genes , , and . In addition, is necessary for normal cell wall integrity. Furthermore, the deletion of resulted in a reduction in the ability of to adhere to surfaces, decreased thermotolerance, as well as increased sensitivity to oxidative stress. Metabolomics analysis indicated that deletion or overexpression led to alterations in the production of multiple secondary metabolites, including gliotoxin. This was accompanied by changes in the expression of genes in the corresponding secondary metabolite gene clusters. These effects could be, at least in part, due to the observed reduction in the expression levels of the and global regulators when the locus was altered. Importantly, our study shows that is indispensable for virulence in both neutropenic and corticosteroid-immunosuppressed mouse models.
是曲霉病的主要病因,与高死亡率相关,尤其是在免疫功能低下的个体中。为了寻找针对曲霉病的新基因靶点,我们研究了WOPR转录因子OsaA。该基因的缺失导致菌落生长减少。分生孢子形成也受其影响;基因缺失和过表达均导致孢子产量下降。OsaA的野生型表达水平对于分生孢子形成调控基因brlA、abaA和wetA的表达是必需的。此外,OsaA对于正常的细胞壁完整性是必需的。此外,OsaA的缺失导致其附着于表面的能力降低、耐热性下降以及对氧化应激的敏感性增加。代谢组学分析表明,OsaA的缺失或过表达导致多种次级代谢产物(包括胶霉毒素)的产生发生改变。这伴随着相应次级代谢产物基因簇中基因表达的变化。这些影响至少部分可能是由于当OsaA基因座改变时观察到的全局调节因子LaeA和VelB表达水平的降低。重要的是,我们的研究表明,在中性粒细胞减少和皮质类固醇免疫抑制的小鼠模型中,OsaA对于毒力都是不可或缺的。